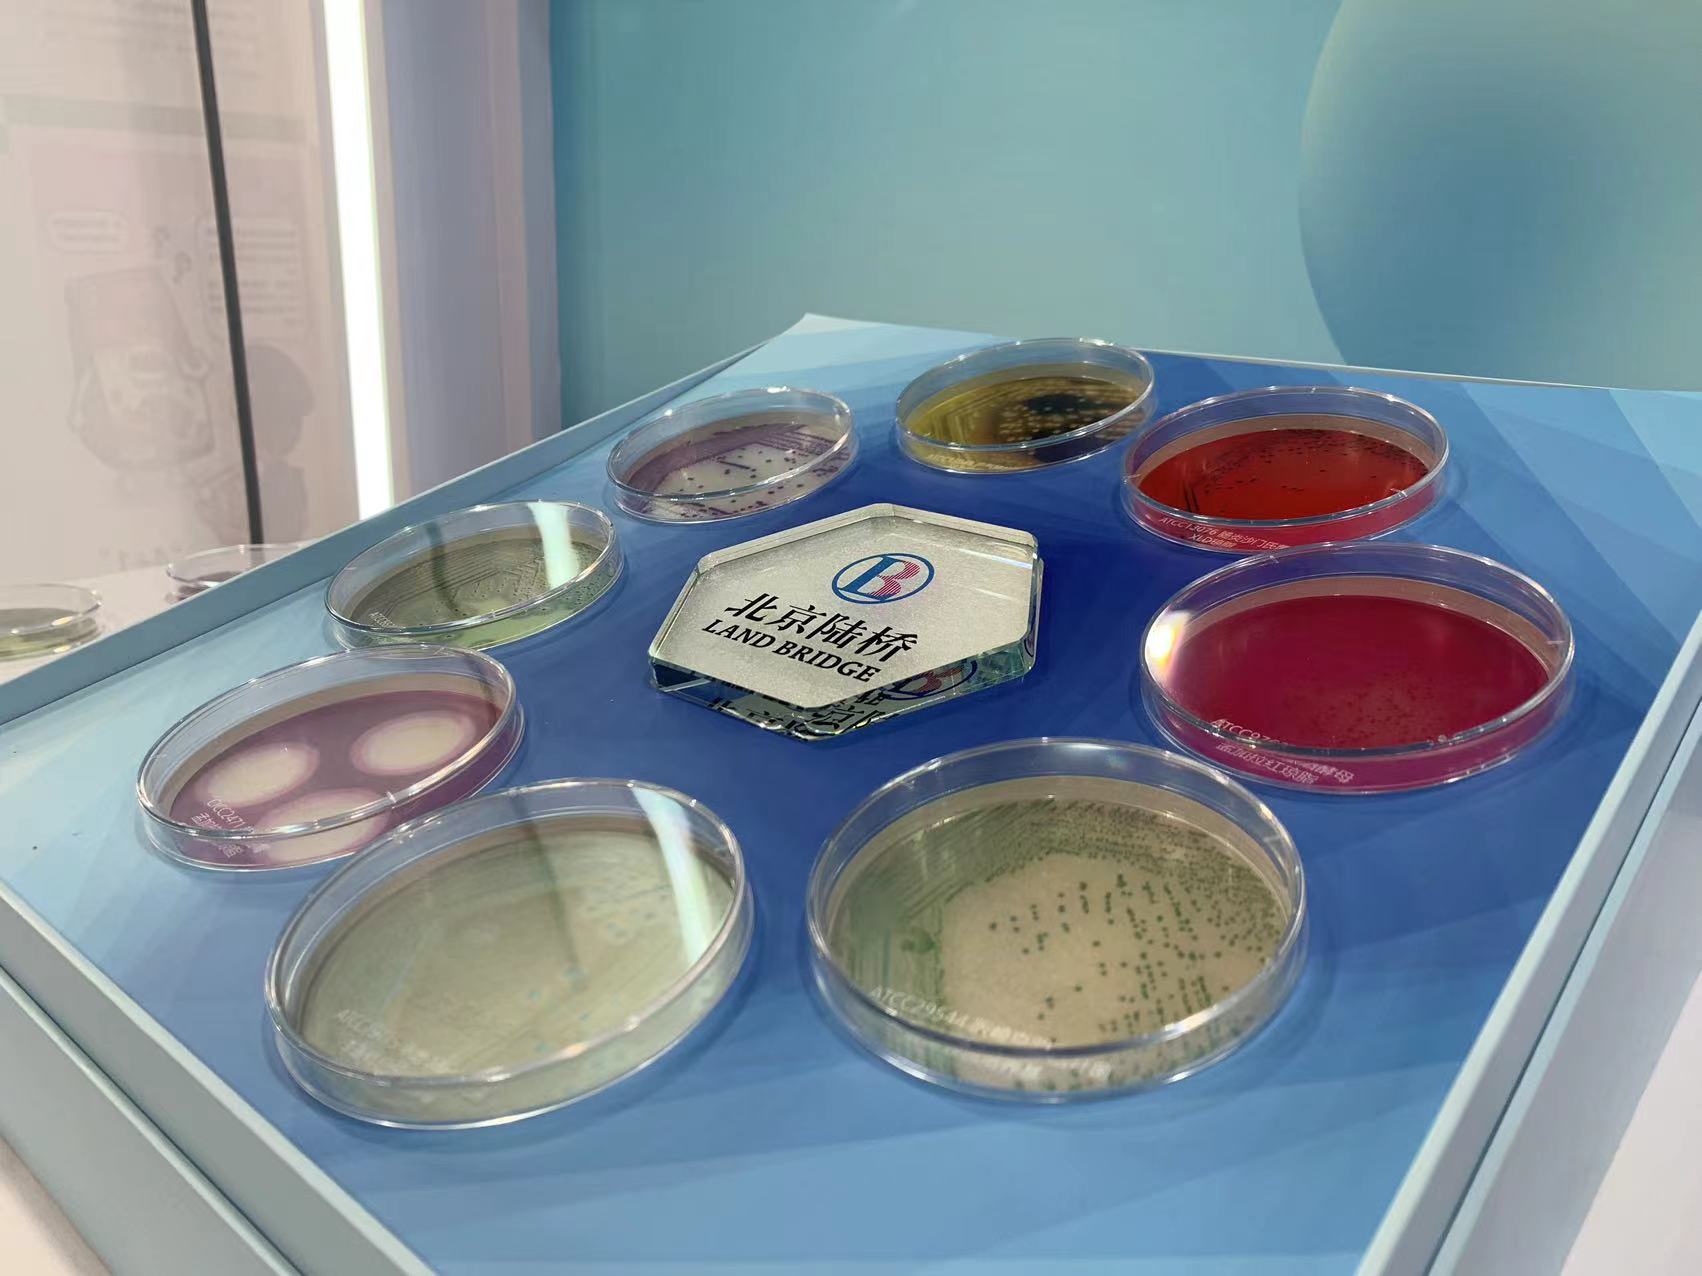

由中國科協(xié)和北京市人民政府會(huì)同20個(gè)國家部委聯(lián)合主辦的第20個(gè)全國科普日主場(chǎng)活動(dòng)將于2023年9月16-24日在北京石景山首鋼園舉辦,主題是“提升全民科學(xué)素質(zhì)�,助力科技自立自強(qiáng)”。

展覽將匯聚全國104個(gè)單位的360個(gè)展項(xiàng),分為五個(gè)部分:領(lǐng)航掌舵鑄輝煌����、自信自立強(qiáng)國夢(mèng)、科學(xué)技術(shù)惠民生��、科學(xué)普及嘉年華�����、科學(xué)教育做加法�����,以及戶外應(yīng)急科普體驗(yàn)區(qū)�、國際科學(xué)傳播交流區(qū)和元宇宙VR體驗(yàn)空間���。
中國檢科院將攜“舌尖上的安全”展項(xiàng)參加科普日活動(dòng)�。北京陸橋也將亮相于檢科院展臺(tái)����,為推動(dòng)科學(xué)發(fā)展和普及科學(xué)知識(shí)助力�。
在此次活動(dòng)上,北京陸橋?qū)⒄故旧嗉馍系陌踩⑸餀z測(cè)�����、真菌毒素與農(nóng)獸藥檢測(cè)產(chǎn)品���。活動(dòng)現(xiàn)場(chǎng)會(huì)有技術(shù)人員給大家進(jìn)行產(chǎn)品演示和講解����。


同時(shí)�����,您也可以與我們進(jìn)行農(nóng)獸藥殘留�����、真菌毒素檢測(cè)的操作互動(dòng)�����。

而為了使觀眾更直觀的了解微生物的形態(tài)等特征,可能出現(xiàn)在日常哪些食物上及食用后的影響���,現(xiàn)場(chǎng)還會(huì)安排人員展示微生物菌落圖卡及講解�。
? ? ? ? ? ? ? ? ? ? ? ? ? ? ? ? ? ? ? ? ? ? ? ? ? ? ? ? ? ? ? ? ? ? ? ??

微生物科普展示卡
北京陸橋與您相約首鋼文化產(chǎn)業(yè)園11號(hào)館���,讓我們一起加入這場(chǎng)科學(xué)盛宴�����,感受科技與科學(xué)的魅力,期待您的蒞臨與交流�。